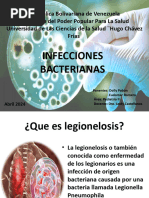

0% encontró este documento útil (0 votos)
77 vistas33 páginasTema 9 Bacilos G Negativos Bartonella y Otros
Este documento describe varios géneros de bacilos Gram negativos espirales, incluyendo Campylobacter, Helicobacter, Brucella, Bartonella, Haemophilus y Legionella. Se proporciona información sobre la epidemiología, patogenia, manifestaciones clínicas, diagnóstico y tratamiento de cada género.
Cargado por
MaripazDerechos de autor
© © All Rights Reserved
Nos tomamos en serio los derechos de los contenidos. Si sospechas que se trata de tu contenido, reclámalo aquí.
Formatos disponibles
Descarga como PDF, TXT o lee en línea desde Scribd
Temas abordados
- Brucella,
- infecciones por agua,
- síntomas sistémicos,
- diagnóstico microbiológico,
- infecciones por alimentos,
- manifestaciones clínicas,
- Bacteroides,
- bacterias gram negativas,
- enfermedades tropicales,
- infecciones zoonóticas
0% encontró este documento útil (0 votos)
77 vistas33 páginasTema 9 Bacilos G Negativos Bartonella y Otros
Este documento describe varios géneros de bacilos Gram negativos espirales, incluyendo Campylobacter, Helicobacter, Brucella, Bartonella, Haemophilus y Legionella. Se proporciona información sobre la epidemiología, patogenia, manifestaciones clínicas, diagnóstico y tratamiento de cada género.
Cargado por
MaripazDerechos de autor
© © All Rights Reserved
Nos tomamos en serio los derechos de los contenidos. Si sospechas que se trata de tu contenido, reclámalo aquí.
Formatos disponibles
Descarga como PDF, TXT o lee en línea desde Scribd
Temas abordados
- Brucella,
- infecciones por agua,
- síntomas sistémicos,
- diagnóstico microbiológico,
- infecciones por alimentos,
- manifestaciones clínicas,
- Bacteroides,
- bacterias gram negativas,
- enfermedades tropicales,
- infecciones zoonóticas